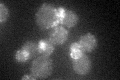
YDL161W

View description
Epsin-like protein involved in endocytosis and actin patch assembly and functionally redundant with Ent2p; binds clathrin via a clathrin-binding domain motif at C-terminus
Localization:
Intensity:
Fold change:
Significance:
-
C’ GFP library in SD
punctate37.62 -
N' NOP1pr-GFP in SD

punctate,bud neck100.977 -
N' TEF2pr-mCherry in SD

punctate,bud neck107.131 -
N' NATIVEpr-GFP in SD

punctate,bud neck40.9073 -
N' TEF2pr-VC and Cyto-VN in SD

cytosol,punctate45.5039 -
C’ GFP library in SD+DTT

punctate40.821.08No -
C’ GFP library in SD+H2O2

punctate41.671.1No -
C’ GFP library in Starvation Media

punctate50.981.35Yes -
C’ GFP library on the background of Pup2-DaMP

punctate -
C’ GFP library on the background of CCT mutant

punctate45.17261.20059No
